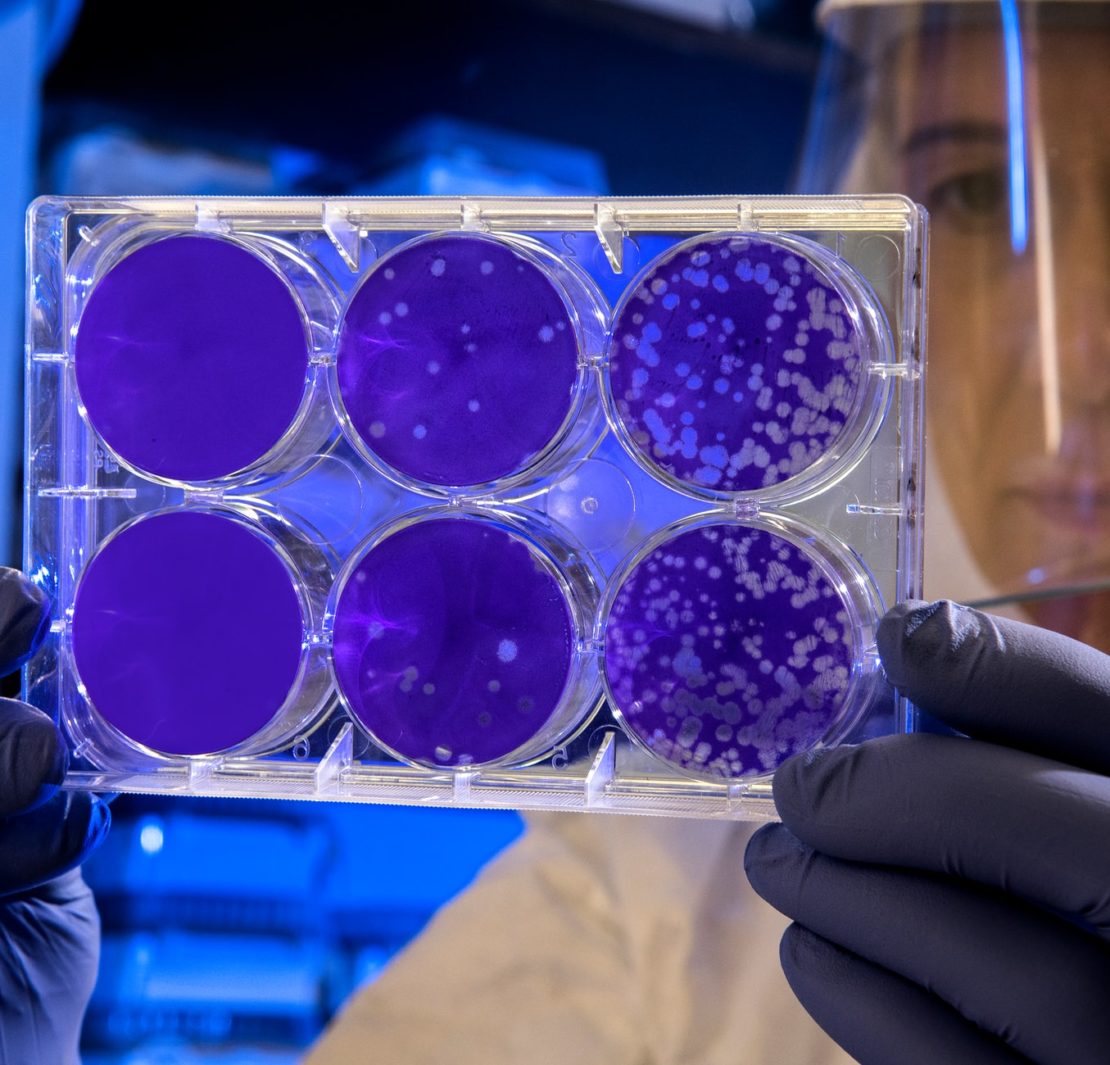
COVID-19 Experts

Les pandémies, de par leur nature, ne restent pas immobiles. Depuis notre premier article «Docteur répond au TOP 10 Question sur le Coronavirus», le nombre mondial de cas confirmés de COVID-19 a beaucoup évalué, tout comme le nombre de décès.
La situation évoluant et se transformant, nous vous avons collecté ce que disent les experts. Quelles sont leurs principales préoccupations et quels sont, selon eux, les défis les plus importants.
Changement d’attitude
Cynthia Taylor Chavoustie, une assistante médicale expérimentée, veut que les gens sachent qu’ils n’ont pas besoin d’avoir peur. «Soyez vigilante, oui, mais effrayée, non», dit-elle.
Elle explique qu’environ 80% des personnes infectées par le SRAS-CoV-2 présenteront «un cas léger ou aucun symptôme. »
Elle nous rappelle cependant que ce n’est pas fini et que «ce n’est pas le moment de baisser la garde. N’ayez pas peur, mais soyez intelligent et soyez vigilant. «
Alors que la pandémie progresse, Chavoustie a développé un respect méfiant pour le SRAS-CoV-2: «Il s’agit d’un virus intelligent. Il a trouvé un moyen de se transmettre sans être détecté pour avoir la plus large diffusion possible. Nous devrions tous avoir un tout nouveau respect pour les virus. Plus important encore, nous devons tous prendre au sérieux le lavage des mains et d’autres habitudes saines pour éviter la propagation. »
Quant aux préoccupations, elle s’inquiète du «manque de traitement ou de gestion efficace des symptômes sévères jusqu’à présent. Pour l’instant, il n’y a pas de méthode rapide ou même claire pour renverser la situation. »
Chavoustie s’inquiète également du fait que la politique « semble influencer tout cela et éventuellement entraver les progrès de l’élaboration d’un vaccin et d’une stratégie de traitement ».
Une concentration sur les tests
Au cours des dernières semaines, les tests de dépistage du SARS-CoV-2 sont passés au premier plan dans l’esprit des scientifiques, des politiciens et du public. Le Dr Michael Virata, un spécialiste des maladies infectieuses. « Au cours du dernier mois, j’ai beaucoup appris sur COVID-19, que ce soit d’un point de vue clinique ou de la manière dont le monde fait face à une pandémie », explique-t-il. « Cette maladie a de nombreuses caractéristiques uniques, et nous nous efforçons de comprendre comment le corps réagit. »
«L’un des éléments clés de la gestion de la pandémie a été le déploiement des tests. Je souhaite que les patients puissent comprendre à quel point il est difficile de trouver le test le plus approprié. »
Les tests sont importants pour suivre les cas et comprendre le fonctionnement de la maladie. Le Dr Virata espère que les scientifiques « auront bientôt un test sérologique fiable et précis, car nous sommes tout à fait certains qu’il y a eu un certain nombre de porteurs asymptomatiques dans la communauté. »
Il souhaite également que le public comprenne «le long processus de trouver le bon traitement. Tout le monde est pressé de dire qu’un médicament est la clé. Mais ce dont nous avons vraiment besoin, c’est d’une recherche solide avec des essais cliniques randomisés qui aident à déterminer les meilleures solutions. »
La santé mentale en confinement
Les habitants de la planète sont maintenant bloqués depuis plusieurs semaines. Pour la grande majorité d’entre nous, il s’agit d’un mode de vie entièrement nouveau. Il est donc nécessaire de nécessiter quelques ajustements.
Outre les effets physiques du virus, de nombreux experts commencent à s’intéresser aux aspects psychologiques de cette «nouvelle normalité».
Le Dr Alex Klein, spécialiste en psychiatrie, veut que les gens sachent qu’il faut se calmer pendant ces temps.
« Laissez-vous ralentir, trouvez des moments pour vous concentrer sur la gratitude même en ces temps difficiles. Ne soyez pas dur avec vous-même si vous n’êtes pas aussi productif que vous le souhaitez », explique-t-il. « Et ne vous sentez pas coupable si vos enfants passent trop de temps devant l’écran. »
La «nouvelle normalité»
Deborah Wetherspoon, Ph.D., infirmière en pratique avancée et enseignante en sciences infirmières à l’université, parle de ce à quoi nous devrions nous attendre alors que notre vie continue aux côtés du SRAS-CoV-2.
«La chose à retenir en ce moment est que c’est un nouveau virus, et personne n’y est naturellement immunisé. Votre système immunitaire le combat et gagne ou non. »
Rester à la maison ne consiste pas seulement à se protéger, explique Wetherspoon. « Le principal objectif du confinement à la maison est d’empêcher tout le monde de tomber malade en même temps. Et de submerger nos systèmes de santé ».
Même si nous arrivons à une nouvelle normale, dit-elle, notre comportement devra changer, car nous devrons «continuer à faire preuve de vigilance raisonnable avec les masques, le lavage des mains et d’autres précautions pour maintenir la courbe des taux d’occurrence aussi plate que possible. De cette façon, si vous avez la malchance d’avoir besoin de soins hospitaliers, ils seront à votre disposition».
Dans le même esprit, la pédiatre Dre Karen Gill nous rappelle également que nous devons rester vigilants. «Le port d’un masque ne remplace pas d’autres mesures éprouvées de contrôle des infections, comme le lavage des mains et rester à la maison lorsque vous êtes malade», explique-t-elle.